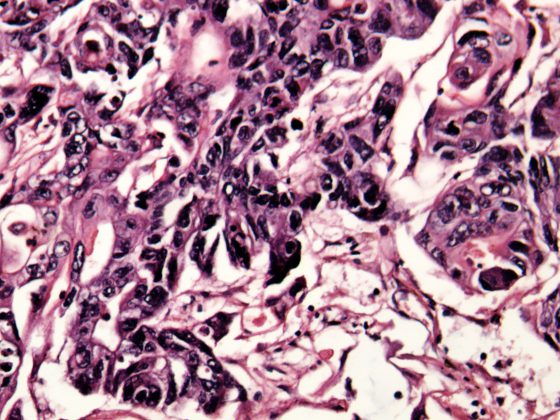

L’Aloe vera è una pianta con proprietà medicinali e cosmetiche molto interessanti. Poiché molto spesso vengono presentati in modo unilaterale ed esagerato nella pubblicità, molti esperti non si occupano delle possibilità documentate di questa pianta medicinale. Tuttavia, vale la pena di studiare in dettaglio la letteratura esistente. Esistono studi seri che dimostrano che l’uso di preparati a base di aloe vera, soprattutto gel, può ottenere risultati notevoli.
La “pianta miracolosa
Su Internet e negli articoli di marketing di alcune aziende, molte piante vengono presentate come “piante miracolose” o come piante dagli effetti miracolosi. L’Aloe vera è una di queste piante. Su internet si possono leggere dichiarazioni euforiche al riguardo, come chiarisce questa descrizione scelta a caso: “L’Aloe vera è una pianta medicinale con una tradizione millenaria. Che si tratti di trattamento di ferite, malattie della pelle, disturbi gastrointestinali, dolori articolari, infiammazioni gengivali o scottature solari: l’Aloe vera è IL tuttofare della naturopatia. Molti effetti sono stati confermati scientificamente da tempo, per cui nessun armadietto dei medicinali dovrebbe esserne sprovvisto”. (www.zentrum-der-gesundheit.de).
Purtroppo, negli ambienti professionali, questi elogi hanno spesso l’effetto opposto a quello desiderato. Le promesse esagerate di guarigione, unite ai riferimenti all’efficacia “scientificamente confermata da tempo”, fanno sì che molti professionisti si allontanino del tutto dal tema. E poi non fanno alcuno sforzo per separare il grano dalla pula, cioè per verificare quale efficacia scientificamente documentata abbia effettivamente la pianta medicinale corrispondente e come possa essere utilizzata con successo.
Aloe vera
Ma che tipo di pianta è l’aloe vera? E qual è la loro efficacia clinicamente documentata? – Qualcosa del “grano” deve essere presentato qui. L’attenzione si concentra sulle possibilità cosmetiche e sulle applicazioni mediche che sono state dimostrate nella letteratura di ricerca. Verranno presentati alcuni studi tipici, senza poter coprire in modo esaustivo la letteratura pubblicata.
Botanica
L’Aloe vera (Aloe barbadensis) è una pianta della famiglia delle erbe (Xanthorrhoeaceae). La pianta ha fino a 16 foglie che crescono fino a 40-50 cm di lunghezza e sono disposte a rosetta contro il fusto (Fig. 1). La patria originaria dell’Aloe è probabilmente l’area intorno all’Arabia Saudita e allo Yemen, ma oggi la pianta cresce anche nell’Europa meridionale e in Asia. Inoltre, esistono colture di aloe nelle regioni tropicali e subtropicali. Sono note dal punto di vista medico l’Aloe barbadensis, chiamata anche Aloe di Curaçao, e l’Aloe ferox, chiamata anche Aloe del Capo.

Applicazioni mediche
La pubblicità parla soprattutto delle proprietà benefiche del succo di aloe vera sulla pelle. Quali sono le proprietà cosmetiche e medicinali?
Utilizzato da secoli come lassativo: Un effetto indiscusso dell’aloe è noto da secoli: Dal succo addensato si ricava un lassativo, che ha un effetto lassativo forte e rapido grazie agli ingredienti antrachinonici. Oltre all’Aloe barbadensis, anche l’Aloe ferox può essere utilizzata a questo scopo. Un tempo l’Aloe era un componente di molti lassativi. Tuttavia, i lassativi contenenti antrachionone sono stati oggetto di critiche ingiustificate a causa dei presunti effetti collaterali dannosi per l’intestino e del potenziale di dipendenza. Tuttavia, oggi ci sono solo pochi farmaci lassativi che hanno l’aloe come ingrediente.
Effetto antiflogistico e guarigione delle ferite: uno studio iraniano riporta un’applicazione della medicina tradizionale persiana in cui le ustioni di secondo grado artificialmente indotte sui ratti sono state trattate con una miscela di latte, miele e succo di aloe vera ed esaminate il primo, il 14° e il 28° giorno dopo l’evento [1]. Rispetto a un gruppo di controllo, il farmaco dello studio ha determinato una guarigione migliore, accelerando la proliferazione cellulare e la chiusura della ferita e portando a una maggiore densità di fibre di collagene. Tuttavia, la limitazione di questo studio è che il succo di aloe vera non è stato testato da solo, ma in combinazione con latte e miele. Quindi gli altri due componenti potrebbero aver contribuito in modo significativo alla cura.
Acne vulgaris: sempre in Iran, è stato condotto uno studio clinico [2] che ha confrontato l’efficacia di una terapia combinata con tretinoina e aloe vera con l’efficacia della sola tretinoina. In questo studio comparativo randomizzato, in doppio cieco, 60 soggetti con acne vulgaris da lieve a moderata sono stati trattati per otto settimane con una combinazione di crema alla tretinoina (0,05%) insieme a un gel di aloe vera (50%) o con la sola crema alla tretinoina.
La combinazione di tretinoina e aloe vera è risultata significativamente più efficace della sola tretinoina in termini di lesioni cutanee infiammatorie (p=0,011), non infiammatorie (p=0,001) e totali (p=0,003) legate all’acne.
Applicazioni cosmetiche: Gli spot pubblicitari, i volantini promozionali e gli articoli di marketing travestiti da documenti scientifici che promuovono le preparazioni a base di aloe vera fanno per lo più riferimento agli effetti cosmetici dei gel e dei succhi. Questi gel dovrebbero levigare la pelle e ritardare o addirittura arrestare il processo di invecchiamento. Ci sono alcuni studi che hanno esaminato questi effetti cosmetici dell’aloe vera. La maggior parte delle pubblicazioni sono studi farmacologici condotti in vitro o in vivo.
Nanostrutture
Le sostanze elaborate in nanostrutture sembrano avere un vantaggio aggiuntivo per l’effetto benefico sulla pelle. Uno studio pubblicato di recente descrive questo processo in dettaglio [3]. L’effetto idratante e levigante della pelle dei preparati a base di aloe vera è documentato anche lì. Quando un gel a base di aloe vera viene incorporato in una nanostruttura, il suo effetto cosmetico aumenta nel processo.
Stimolazione dei fibroblasti
Un recente studio pubblicato da un team di Taiwan riporta l’effetto protettivo dell’aloe sullo stress ossidativo indotto dal calore sui fibroblasti [4]. Lo stesso effetto del gel di aloe vera è riportato da Tanaka et al. che nella loro pubblicazione [5] descrivono una combinazione di uno studio in vitro con uno studio clinico. Nello studio in vitro, hanno analizzato la capacità del succo di aloe vera di stimolare i fibroblasti della pelle umana. Questi aumentano la formazione di collagene e acido ialuronico da una volta e mezza a due volte, grazie all’influenza del succo. L’effetto benefico sulla pelle è attribuito ai seguenti ingredienti nello studio di Tanaka et al: Polisaccaridi, aminoacidi, lipidi, steroli e tannini. Acemannan è (Fig. 2) è il polisaccaride più importante dell’Aloe vera.

Nella seconda parte dello studio, randomizzato, in doppio cieco e controllato con placebo, hanno somministrato una polvere di aloe vera contenente 40 microgrammi di steroli di aloe ma quasi nessun antrachinone a donne giapponesi di oltre 40 anni, ogni giorno per otto settimane. Al termine dello studio, è stato osservato un moderato aumento dell’idratazione cutanea nel gruppo verum rispetto al gruppo placebo. Tuttavia, la differenza non ha mostrato alcuna significatività. In una valutazione di sottogruppo, tuttavia, è stata determinata una differenza significativa nella dimensione delle pieghe cutanee a favore del gruppo verum.
Uno studio pubblicato nel 2009 ha mostrato un risultato simile [6]. Il team di ricerca guidato da Takahashi ha incorporato il succo di aloe vera nei liposomi per aumentare la biodisponibilità. Questi liposomi con un diametro inferiore a 200 nm contenevano varie concentrazioni di gel di aloe vera. Sono stati poi uniti ai fibroblasti cutanei neonatali per verificare il loro effetto sulla proliferazione della sintesi di collagene. Questo gel di aloe vera liposomiale ha causato un tasso di proliferazione significativamente più alto rispetto al gel di aloe vera non incorporato nei liposomi. I ricercatori hanno osservato lo stesso effetto quando hanno esaminato la proliferazione dei cheratinociti con il gel liposomiale da un lato e con il normale gel di alo-vera dall’altro.

Sommario
Se, nonostante il diluvio di lodi euforiche, si sforza di trovare studi seri sull’efficacia dell’aloe vera, sarà ricompensata: oltre all’effetto lassativo dell’aloe vera, noto da secoli, le proprietà cicatrizzanti e antinfiammatorie sono considerate assicurate; è stata dimostrata anche la sua efficacia nell’alleviare l’acne vulgaris.
Anche l’effetto cosmetico del succo di aloe vera, o delle preparazioni corrispondenti, è stato documentato in alcuni studi: Quando l’aloe vera viene incorporata nei liposomi, che sono presenti come nanoparticelle e stimolano i fibroblasti, questo porta ad una migliore idratazione della pelle e può levigare la pelle.
Letteratura:
- Farzadina P, et al: Attività antinfiammatorie e di guarigione delle ferite dell’unguento di Aloe vera, miele e latte sulle ustioni di secondo grado nei ratti. Int J Low Extrem Wounds 2016, 23 maggio. doi: 10.1177/1534734616645031. [Epub ahead of print]
- Hajhedari Z, et al: Effetto del gel topico di Aloe vera combinato con la tretinoina nel trattamento dell’acne vulgaris lieve e moderata: uno studio prospettico randomizzato, in doppio cieco. J Deramtol Treat 2014(2); 25: 123-129.
- Palanivel G, Dong-Kug C.: Applicazione attuale dei nanocosmeceutici a base di fitocomposti per la bellezza e la terapia della pelle. International Journal of Nanomedicine 2016 May 11; 11: 1987-2007. doi: 10.2147/IJN.S104701. eCollection 2016.
- Liu FW, et al: L’aloina protegge i fibroblasti cutanei dal danno da stress ossidativo indotto dallo stress termico, regolando il sistema di difesa ossidativo. PLoS One 4 dicembre; 10(12): e0143528. doi: 10.1371/journal.pone.0143528. eCollection 2015.
- Tanaka M, et al.: Effetti degli steroli vegetali derivati dal gel di Aloe vera sui fibroblasti dermici umani in vitro e sulla condizione della pelle nelle donne giapponesi. Dermatologia clinica, cosmetica e sperimentale 2015; 8: 95-104.
- Takahashi M, et al: I liposomi che incapsulano l’estratto di gel di foglie di Aloe vera aumentano significativamente la proliferazione e la sintesi di collagene nelle linee cellulari della pelle umana. J Oleo Sci 2009(12); 58: 643-650.
PRATICA GP 2016; 11(9): 2-3